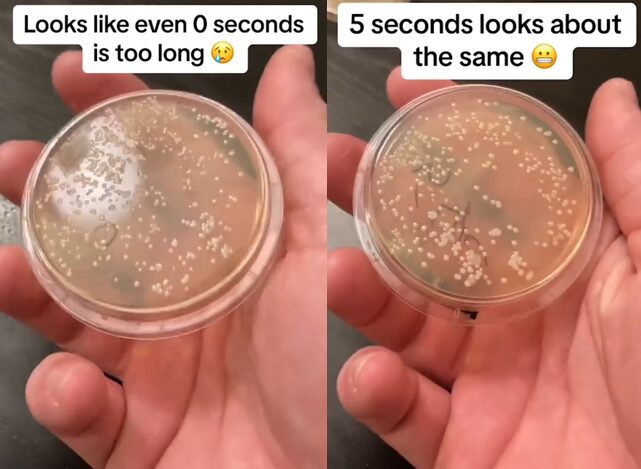

바닥에 떨어진 음식, 5초 안에 주우면 괜찮다는 속설. 한 번쯤 들어봤을 것이다. 정말일까? 한 미생물학자가 이에 대해 실험한 결과를 공유했다.
영국 매체 데일리메일에 따르면, 미국의 미생물학자 니콜라스 아이허는 음식이 바닥에 닿는 순간부터 이미 박테리아 오염이 시작된다는 사실을 밝혀냈다. 그가 공유한 실험 영상은 100만 회 이상 조회되며 큰 관심을 모았다. 그는 자신의 집 바닥에 음식을 떨어뜨린 후 각각 1초, 5초, 10초, 20초, 30초, 1분 뒤 채취한 샘플을 배양 접시에 옮겼다. 그런 다음 접시를 배양기에 넣어 박테리아가 얼마나 자라는지 확인했다.
일정 시간 후 확인한 결과, 모든 샘플에서 백색 박테리아가 증식한 것으로 확인됐다. 특히, 1초 샘플에서도 5초 동안 바닥에 놓였던 샘플과 큰 차이가 없는 수준의 박테리아가 관찰됐다. 그는 “심지어 0초도 너무 길었다”며 “5초든 60초든, 어느 쪽이든 끔찍할 것”이라고 말했다.
또한 그는 실험 도중 실수로 5초 샘플을 떨어뜨렸는데, 대부분의 박테리아가 나무 테이블로 고스란히 옮겨 붙는 모습이 포착돼 오염이 주변 환경에까지 확산될 수 있음을 보여다.
영상을 본 누리꾼들은 “다시는 바닥에 떨어진 음식을 먹지 않을 것이다”, “어렸을 때부터 5초 룰을 지켰는데 아직 건강하다” 등 다양한 반응을 보였다.
장염, 식중독 등 유발하고 심한 경우 합병증까지…비위생적인 음식 섭취 피해야
전문가들은 바닥에 떨어진 음식을 먹는 행동이 단순히 불쾌함을 넘어 식중독을 유발할 수 있다고 말한다. 심각한 질병을 일으킬 수 있는 박테리아에 감염될 위험이 존재하기 때문이다. 특히, 수박이나 사과 등 수분이 있는 음식은 건조 식품보다 더 빠르게 박테리아를 끌어들인다.
대표적으로 살모넬라균, 리스테리아균과 같은 박테리아는 음식에 닿자마자 즉시 증식하며 장염이나 식중독과 같은 질병을 일으킬 수 있다. 살모넬라균에 의해 발병하는 장티푸스는 적절한 치료를 받지 않으면 심각한 합병증으로 이어질 수 있다. 리스테리아균 역시 면역력이 약한 사람들에게 패혈증, 수막염 등 심각한 상황을 초래할 수 있다.
이러한 질환은 일반적으로 오염된 음식을 섭취한 후 24시간 이내에 복통, 메스꺼움, 구토, 두통, 설사 등의 증상을 나타낸다. 따라서 음식 섭취로 인한 증상으로 의심될만한 징후가 나타나면 즉시 치료를 받아야 한다. 또한 평소 손씻기, 비위생적인 음식 섭취 피하기 등 개인 위생을 지키도록 한다.





